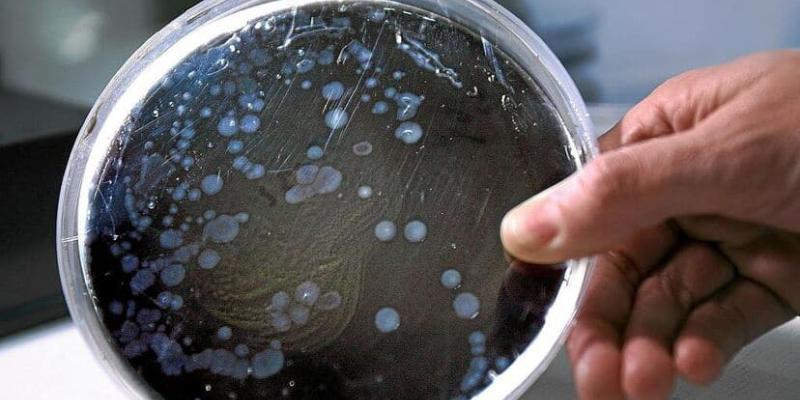
Aumentan los casos de esta nueva bacteria

Lectura fácil
Un estudio realizado por el Hospital de Bellvitge ha alertado sobre un aumento en los casos graves de infecciones provocadas por la bacteria Streptococcus dysgalactiae subsp. equisimilis (SDSE) en España. Esta infección forma parte de la microbiota humana, es decir, suele convivir con nosotros sin causar problemas, pero en determinadas condiciones puede desencadenar infecciones graves, especialmente en personas con un sistema inmunológico debilitado.
El estudio acerca de la nueva bacteria contra la salud
La investigación fue publicada en la prestigiosa revista International Journal of Infectious Diseases y se realizó entre 2012 y 2022, analizando más de 100 casos registrados en ese periodo.
El trabajo fue liderado por el Instituto de Investigación Biomédica de Bellvitge (Idibell) y contó con la colaboración de diversos centros de investigación, entre ellos el Hospital General Universitario Gregorio Marañón en Madrid, el Hospital Universitario de Donostia en el País Vasco y otras instituciones internacionales, como el Hospital Houston Methodist en Estados Unidos y la Université de Lorraine en Francia.
Los resultados del estudio indican que la bacteria está afectando principalmente a personas mayores de 70 años y a pacientes con enfermedades crónicas, tales como diabetes, patologías cardiovasculares o cáncer. Además, los casos siguen aumentando.
Además, los investigadores advirtieron que algunas cepas de la bacteria están mostrando resistencia a los antibióticos más comunes, lo que dificulta su tratamiento y aumenta la gravedad de las infecciones.
Un fenómeno global y aumento de casos
La jefa de sección del Servicio de Microbiología del Hospital de Bellvitge e investigadora del Idibell, la doctora Carmen Ardanuy, destacó que este aumento de infecciones no es un fenómeno aislado de España. En varios países del mundo se ha observado un patrón similar.
La doctora señaló que la resistencia a los antibióticos es un problema creciente y urgió a continuar con la investigación para comprender mejor cómo evoluciona la bacteria y cómo prevenir la propagación de cepas más virulentas y resistentes.
El estudio también reveló que los investigadores han utilizado técnicas avanzadas de secuenciación genómica para estudiar la infección. Gracias a estas herramientas, han podido identificar los complejos clonales CC15, CC17 y CC20 como los más predominantes.
De hecho, se descubrió que la variante CC20-stG62647 tiene una mayor capacidad para causar enfermedades graves, según los modelos animales empleados en el estudio.
Resistencia a los antibióticos
Uno de los principales retos que enfrentan los profesionales de la salud es la resistencia de algunas cepas de SDSE a los antibióticos. En el estudio se observó que los macrólidos, que son antibióticos comúnmente utilizados como segunda opción, han visto reducida su efectividad en el tratamiento de estas infecciones.
En cambio, los investigadores hallaron que alternativas como el linezolid y la delafloxacina son más efectivas para combatir la bacteria.
Necesidad de más investigación
Guillem López de Egea, primer firmante del artículo, concluyó que este trabajo es un paso importante para entender la evolución del Streptococcus dysgalactiae y las herramientas que tenemos para enfrentarlo.
Sin embargo, insistió en que aún queda mucho por hacer para frenar su expansión y prevenir los efectos de las cepas más resistentes.
El aumento de infecciones graves por Streptococcus dysgalactiae en España refleja una tendencia preocupante que también se observa a nivel global. Es fundamental seguir investigando para comprender cómo evoluciona esta bacteria y desarrollar tratamientos más efectivos.
La prevención y el manejo adecuado de las infecciones causadas por SDSE son cruciales, especialmente para las personas más vulnerables, como los mayores de 70 años y aquellos con enfermedades crónicas.



Añadir nuevo comentario